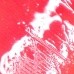
02

Kathy Amrez
Juicy Tint Serum
0.0

Kathy Amrez
Juicy Tint Serum
Product Detail
ใหม่! ลิปทิ้นกลอสซีรั่ม มีถึง 4 เฉดสีสวย น่ารัก
สีชัดติดทน 48 ชม. พร้อมบำรุงล้ำลึก ปากนุ่มฟู ไม่ลอกไม่แห้ง แถมติดทนแบบจูบไม่หลุด!
พร้อมนวัตกรรม กลอสออยล์สุดวาว ไม่เหนียวเหนอะหนะ เบาสบายปาก สารสกัดบำรุงอัดแน่นจาก Carrot extract, Sunflower seed oil, Organic argan oil, Organic camelia Oil และสารสกัดจากผลไม้ 7 ชนิด!!
มี 4 เฉดสี สุดฮิต
01 สีแดงเชอร์รี่ - CHERRY
สีแดงก่ำ ให้ลุคสาวมั่น สุดแซ่บ ทาด้านในปาก ไล่สีคือสวยมาก สีที่ทุกคนต้องมี
02 สีพีช- PEACH
สีพีชน่านักมาก ทาได้ทุกสีผิว สีที่ทาแล้วดูสดใส ย้อนวัยสุดๆ
03 สีส้ม - APRICOT
สีส้มสดใส เกาหลีเกาใจมาก ทาแล้วหน้าไบรท์ ให้ลุคสาวมั่น น่าค้นหาสุดๆ
04 สีชมพู - STRAWBERRY
สีชมพูสุดคิ้วท์ น่ารัก ลุคสาวหวาน ลูกคุณหนู ดูสดใส ทาแล้วหน้าเด็กลงเว่อร์
Colors
0.0
Quick Product Notes
ดูคำธิบายเพิ่มเติม จิ้มที่ชื่อได้เลยนะ :)
Ingredientsดูคำธิบายเพิ่มเติม จิ้มที่ชื่อได้เลยนะ :) | Notes |
|---|
Quick Product Notes
ดูคำธิบายเพิ่มเติม จิ้มที่ชื่อได้เลยนะ :)
Ingredientsดูคำธิบายเพิ่มเติม จิ้มที่ชื่อได้เลยนะ :) | Notes |
|---|
เพิ่มรีวิวของคุณได้ง่ายๆ แค่เพียง 1 นาที